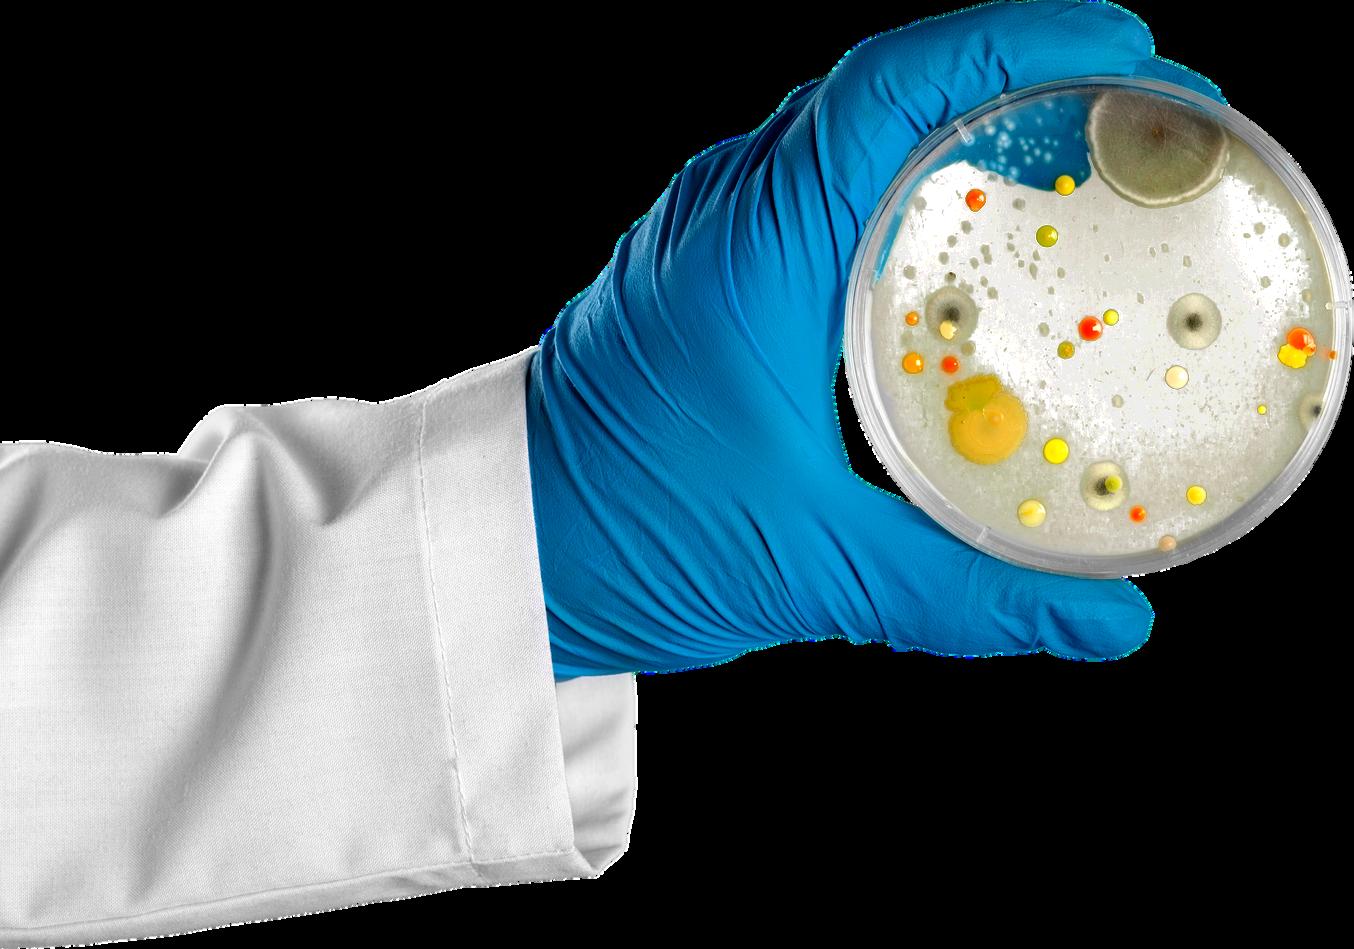

HEALTH SCIENCES RESEARCH REVIEW


HEALTH SCIENCES RESEARCH REVIEW


African scientists lead health research
Faculty Research Day returns with a bang
Assessment of NHI in SA

Measurement of kidney function in Malawi, South Africa, and Uganda

How SA law handles baby swapping
Morality, responsibility & accountability: An Afrocentric approach by African health scientists

14 Nov Public lecture by Dr Jacqueline Weyer | Monkeypox: the emerging health threat
The Newsletter is an opportunity for us to present retrospective research article collections to showcase research excellence from the different disciplines in the Faculty, celebrate staff awards and achievements, highlight upcoming events and share general information
I am pleased to take this opportunity to congratulate a number of our researchers who received prestigious awards for their exceptional contributions to the advancement of research in the period July to September 2022 Firstly, Professor Shabir Madhi was awarded the NSTF South32 Lifetime Award at the ‘Science Oscars’ of South Africa. Secondly, Professor Helen Rees was conferred an Honorary Degree of Doctor of Sciences (Medicine) by the University of London Lastly, the Sydney Brenner Institute for Molecular Bioscience was awarded the NRF Science Team Award for extending the boundaries of scientific research in Africa that is impactful to society


In this issue, we also highlight two Health Sciences Research Office events which were held in August and September. The 18th Prestigious Research Lecture celebrated the MRC/Wits Agincourt Rural Public Health and Health Transitions Research Unit’s (MRC/Wits Agincourt Unit) 30th anniversary, which marks an achievement in a sustained commitment to public health science and research. The Faculty Research Day showcased the important research presented by our tireless researchers and postgraduate students The accompanying Postgraduate Expo was also a success Well done to Dr Joshua Davimes and his team for an exceptional programme! The Faculty and the Research Office convey their congratulations to all the winners and thank all participants for making the day a huge success!
From the activities displayed in this Newsletter, it is evident that research is alive and thriving in the Wits Faculty of Health Sciences! Well done to all for your exceptional contributions and hard work!



Early data indicated that infection with omicron (around 99% BA.1 lineage during this period) was associated with a lower risk of hospitalisation and lower risk of severe illness, once hospitalised, compared with delta (B 1 617 2) variant infection 1 Recently, the BA.2 lineage has increased in many areas globally, including South Africa, associated with increases in case numbers in some settings.

In South Africa, the BA 2 lineage was first detected on Nov 17, 2021 From week 49 of 2021, the proportion of BA 2 lineage began to increase, making up 84% (27 of 32) of all sequenced samples by week 5 of 2022 Replacement of BA.1 by BA.2 occurred in a period when SARS CoV 2 case numbers were declining from the fourth wave peak in South Africa and was associated with a brief increase in case numbers in children of school going age and slowing of the rate of decline compared with previous waves.
The BA 1 lineage contains a 69 70 amino acid deletion in the spike protein, which is associated with S gene target failure (SGTF) when tested using the TaqPath COVID 19 PCR test (Thermo Fisher Scientific, Waltham, MA, USA) At the time of this study, BA 2 lacks this deletion, hence infections with BA 2 are S gene positive on this assay
*Read full study
The paper analysed the breakthrough infection patterns, COVID 19 related hospitalisations (i e hospitalisations of participants who tested positive for COVID 19), and COVID 19 related deaths overall between Feb 17, 2021, and Jan 31, 2022 inclusive of when participants received their first and second doses of Ad26 COV2 S (figure) It also evaluated the frequency and severity of breakthrough infections during the first 78 days, during which participants were predominantly exposed to the delta and omicron variants after a single dose of the Ad26 COV2 S vaccine
*Read full study
Publication Journal: Nature Medicine (87.241)
Treatment outcomes 24 months after initiating short, all-oral bedaquiline-containing or injectable-containing rifampicinresistant tuberculosis treatment regimens in South Africa: a retrospective cohort study

The theory of syndemics has received increasing attention in clinical medicine since the onset of the COVID 19 pandemic, due to the synergistic interactions of the disease with pre existing political, structural, social and health conditions Syndemics are synergistically interacting epidemics that occur in a particular context with shared drivers

The syndemics framework argues that multiple factors synergistically work in tandem, and populations with the highest morbidity and mortality experience the greatest impact of these interactions
The paper discusses the emergence of syndemics, how epidemics interact, and what scientists, clinicians and policymakers can do with this information

*Read full study
There is a need for short and safe all oral treatment of rifampicin resistant tuberculosis This paper compared outcomes up to 24 months after treatment initiation for patients with rifampicin resistant tuberculosis in South Africa treated with a short, all oral bedaquiline containing regimen (bedaquiline group), or a short, injectable containing regimen (injectable group)
*Read full study
Publication Journal: Nature (69 504)
The extent to which Omicron infection with or without previous vaccination, elicits protection against the previously dominant Delta (B.1.617.2) variant is unclear. Here we measured the neutralization capacity against variants of severe acute respiratory syndrome coronavirus 2 in 39 individuals in South Africa infected with the Omicron sublineage BA 1 starting at a median of 6 (interquartile range 3 9) days post symptom onset and continuing until last follow up sample available, a median of 23 (interquartile range 19 27) days post symptoms to allow BA 1 elicited neutralizing immunity time to develop
*Read full study



The 2022 Faculty of Health Sciences Research Day was held on 15 September 2022 This event is positioned bienially as the premier event to showcase the current Wits Faculty of Health Sciences’ staff and student research portfolio




This year’s Research Day was the first time going hybrid with both in person and remote attendees All attendees utilized the Whova mobile and desktop platform to engage live streamed content, network and view exhibitors, sponsors, and the postgraduate expo in conjunction with all in person activities The theme for this year was “Research For Good” in reflection of Wits’ current stance and its 100th celebration.
The day saw nearly 1000 attendees, with around 700 in person, and 300 joining remotely in the research festivities, and the much missed conference chaos after two years of operating in a virtual space. A mass of exhibitors and sponsors put up stands at the Health Sciences Campus and showcased their latest technology, tools, and media to an excited and highly vibrant audience throughout the day
A total of 187 staff and student presentations were included in the programme with 90 oral presentations and 97 poster presentations spread out across five thematic tracks. The day began at the Public Health Auditorium with a welcome and opening address from the chairperson, Dr Joshua Davimes, followed by the Dean, Professor Shabir Madhi’s address on current affairs in the Faculty

The 5th Phillip V Tobias plenary lecture was delivered by Prof Mary Lou Galantino from Stockton University on academic community research during unpredictable times. The talk was fascinating and well received and set the tone for the day
Five parallel breakaway oral sessions took place at the Health Sciences Building with a variety of student and staff orals in all sorts of health sciences disciplines

The day then transformed into 3 parallel round table discussions with topics including Vaccines for Africa (Chaired by SAMRC president Professor Glenda Gray); Trials, tribulations, and contradictions of academia (Chaired by Professor Benita Olivier); and Mental health beyond the pandemic (Chaired by Dr Sandra Fernandes).

These riveting round table sessions then led to the remainder of the day, which included two more parallel breakaway oral sessions, a buzzing and packed poster session, as well as a luncheon with extensive networking.
The 2022 Research Day concluded with the prize giving ceremony in which Aspen Group Senior Executive, Dr Stavros Nicolaou gave a short and poignant address on keeping South African health scientists in South Africa. Awards were presented to the best staff and student oral presentations across the five themes and the research was celebrated over dinner and cocktails before closing

In celebration of the MRC/Wits Agincourt Rural Public Health and Health Transitions Research Unit’s (MRC/Wits Agincourt Unit) 30th anniversary researcher and founding director of the Unit, Professor Stephen Tollman and Professor Kathleen Kahn, a personal professor at the Wits School of Public Health and principal scientist at the MRC/Wits Agincourt Unit presented a prestigious research lecture titled “From Transition to Transformation restoring the dream of ‘health for all’ using community oriented evidence” on the 29th of August 2022
Their lecture kicked off with a rewind to the 1990s when Tollman and Kahn had returned from their studies abroad and made a move to Bushbuckridge in what is today, Mpumalanga Their intention was to better understand the public health needs of largely marginal rural communities
Professors Tollman and Kahn are the dynamic force behind building the Agincourt Health and Socio Demographic Surveillance System a longitudinal rural health research platform into a renowned pillar for rural public health response and research.
Hundreds of PhD students, researchers and collaborators have passed through the Unit’s door over the past three decades, marking the MRC/Wits Agincourt Unit as an ecosystem of local, regional and international research partners and collaborators.
Underpinning all their cohorts, programmes and trials has been working at being better partners with their host communities It has involved for instance, not overlooking the role of traditional healers in public health, or responding to the transience of labour migration, and acknowledging the socio economic neglect of rural communities
Professor Mosa Moshabela, one of many exceptional researchers to pass through the MRC/Wits Agincourt Unit’s door and now Deputy Vice Chancellor of Research and Innovation at the University of KwaZulu Natal, acted as a commentator at the lecture.
In his comments, he honed in on Tollman and Kahn’s personal determination, the applications of their long experience, and their ability to adapt and deliver in the face of all kinds of unexpected circumstances.




in West Asia, with only secondary dispersals of non Anatolian Indo Europeans from the steppe.

Prof Schepartz envisages for Africans to also advance in tracing knowledge on its history of migration adding that “a similar approach would be ideal for examining one of the most important of such movements known the peopling of sub Saharan African by early Bantu language speaking farmers who originated in West Africa and begin to migrate over the last few thousand years”.

The second paper, “Ancient DNA from Mesopotamia suggests distinct Pre Pottery and Pottery Neolithic migrations into Anatolia” seeks to understand how the world’s earliest Neolithic populations formed. It presents the first ancient DNA data for Pre Pottery Neolithic farmers from the Tigris side of northern Mesopotamia both in eastern Turkey and in northern Iraq a prime region of the origins of agriculture It also presents the first ancient DNA from Pre Pottery farmers from the island of Cyprus, which witnessed the earliest maritime expansion of farmers from the eastern Mediterranean
A trio of papers published simultaneously in Science reports on genome-wide data from 727 distinct ancient individuals more than doubling the amount of ancient DNA data from this region and filling in major gaps in the paleogenetic record. A team of researchers together with 202 co authors, including Wits School of Anatomical Sciences researcher, Professor Lynne Schepartz, leverage their data to test longstanding archaeological, genetic and linguistic hypotheses They present a systematic picture of the interlinked histories of peoples across this region from the origins of agriculture to late medieval times.
Schepartz’s three papers on population history and migrations across southern Europe and the Near East illustrate that major multidisciplinary scientific collaborations are needed to trace past human population movements
The homeland and the spread of Anatolian and Indo European languages

The genetic results of the Chalcolithic / Copper Age and Bronze Age periods, presented in their first paper “The genetic history of the Southern Arc: a bridge between West Asia and Europe” , suggest that the homeland of the Indo Anatolian language family was
Furthermore, it provides new data for early Neolithic farmers from the Northwest Zagros, along with the first data from Neolithic Armenia By filling these gaps, the authors could study the genetic history of these societies for which archaeological research documented complex economic and cultural interactions but could not trace mating systems and interactions which do not leave visible material traces



The third paper, “A genetic probe into the ancient and medieval history of Southern Europe and West Asia” reveals how polities of the ancient Mediterranean world preserved contrasts of ancestry since the Bronze Age but were linked by migration
In reflecting on her latest series of work, Prof Schepartz emphasizes that knowledge of migration is based on archaeological evidence and linguistic analyses thus making research in this area an invaluable pursuit “We know some general features of the migration, but many specific details remain open to debate” adding that “ancient DNA studies are becoming important components of research on African populations and future multidisciplinary scientific collaborations across the continent should provide the answers ”
Wits scientists Drs Florette Treurnicht, Jinal Bhiman, Catherine Scheepers and Mrs Ramuth Magalutcheemee (a PhD student from Mauritius) from the Department of Virology in the School of Pathology, made significant contributions to SARSCoV 2/COVID 19 genomics surveillance in South Africa.
Drs Nicole Wolter and Anne von Gottberg, who are affiliated with the Department of Clinical Microbiology and Infectious Diseases at the Wits Faculty of Health Sciences, are also leading SARS CoV 2 genomics surveillance in South Africa, especially for genomics data from other provinces besides the Western Cape, KwaZulu Natal and Gauteng

Ongoing genomics surveillance led to participation in a continent wide collaboration for which the study outcomes will be published in the journal Science and is entitled “A continent wide collaboration on genomics surveillance show the power of African science and how the majority of COVID 19 variants were introduced into Africa”. The study highlights the rapid growth of genomics surveillance in Africa with over 100 000 SARS CoV 2 genomes analysed to characterise variants in real time since the start of the pandemic
More than 300 authors from Africa and elsewhere collaborated on this study, forming the largest
consortium of African scientists and public health institutions working to support data driven COVID 19 response in Africa. This is a great example of how the large investments, collaborations and capacity building strategies in genomic surveillance on the African continent promoted timeous public health response in real time.
The first author, Houriiyah Tegally, a Bioinformatician highlighted the impact of this collaboration as they "witnessed small countries with no previous genomics experience become empowered in sequencing and bioinformatics methods and start to actively participate in regular pathogen genomic surveillance for SARS CoV 2”
Mrs Magalutcheemee, a PhD student in the Department of Virology at Wits and a leading scientist in the National Central Health Laboratory in Mauritius assisted with the implementation of SARS CoV 2 genomics surveillance using the Oxford Nanopore MinION portable next generation sequencing system with subsequent utilisation of the same platform for influenza virus genomics to meet outputs towards her PhD, but ultimately this collaboration allowed her to establish capacity for other respiratory virus genomics surveillance in her country.
full study

One of the main reasons women give up breastfeeding globally is because they need to return to work or school While supporting breastfeeding is good for public health, it also contributes to gender equity and transformation So, how does Wits support female employees and students who wish to continue breastfeeding? This is the main research question of a recently approved study entitled “Institutional Breastfeeding Support at Wits: An Exploratory Qualitative Study”
The University Wellness Forum asked the Faculty of Health Sciences (FHS) Wellness Committee to lead a study to respond to concerns raised at the Forum about breastfeeding support for students and staff The study, designed by the Committee’s Breastfeeding Working Group, is being led by investigators from Public Health, Community Paediatrics and Physiotherapy The Faculty’s Research Office provided Seed Funding of approximately 70K to kick start the process in 2022, with investigators seeking additional funding to extend this university wide study.
The study is using qualitative interviews to explore breastfeeding environment(s) at Wits Interviews with senior managers and decision makers at Wits are exploring legal and policy considerations, infrastructure, social and emotional support and relationships the university has with the formula industry The study is also creating an anonymous space for staff and students to share their breastfeeding experiences.
Data collection is ongoing All staff (academic, administrative and support) are invited to participate along with undergraduate and postgraduate students. To be eligible, you must have given birth over the past five years while employed and/or studying at Wits and must have at least initiated breastfeeding To increase inclusivity, we are sharing study details widely
in the study
Wits researcher involved: Luvuyo Gantsho
Molecular genetic engineering technologies such as CRISPR/Cas9 have made the accurate and safe genetic engineering of human embryos possible. Further advances in genomics have isolated genes that predict qualities and traits associated with intelligence. Given these advances, prospective parents could use these biotechnologies to genetically engineer future children for genes that enhance their intelligence.
While Julian Savulescu’s Principle of Procreative Beneficence (PPB) argues for the moral obligation of prospective parents to use in vitro fertilization and preimplantation genetic diagnosis to make eugenic selections of embryos for intelligence, the PPB could imply obligations to genetically engineer selected embryos for intelligence as well
This paper argues that the PPB implies an additional moral obligation for prospective parents to genetically engineer the embryonic germline identity of selected embryos for genes that predict intelligence Objections to the argument for the PPB’s extension are also discussed
Research into the genetic basis for complex traits such as intelligence has produced fruitful results, with genes predicting mathematical ability and working memory having been singled out While it is broadly acceptable for prospective parents to use in vitro fertilization (IVF) and preimplantation genetic
diagnosis (PGD) to select embryos for severe disease causing genes, or even for non medical reasons, Savulescu argues that prospective parents should select embryos for non medical traits
Do prospective parents have a moral obligation to genetically enhance the germline of their prospective children for intelligence?
This paper argues that prospective parents do have a moral obligation to genetically enhance the germline of their prospective children for intelligence
Arguments for is a pro tanto obligation, and therefore should be considered in the context of, and weighed against, other competing moral obligations for as long as there are monetary costs associated with pursuing GGECE
The argument for the principle of procreative beneficence (PPB)

The PPB is a term first coined by Julian Savulescu and is an argument based on the following propositions: (1) some non disease genes affect the likelihood of us leading the best life; (2) we have good reason to use information which is available about such genes in our reproductive decision making; therefore (C) couples (or single producers) should select embryos or foetuses which are most likely to have the best life, based on available genetic information about non disease genes
After the argument for the PPB’s extension to include genetic engineering, this paper argues and defends the view that genes that predict intelligence contribute toward well being and therefore should be selected for and engineered into selected embryos Read full study
Morality, responsibility & accountability: MAn orality, responsibility & accountability: An Afrocentric approach by health African Ascientists frocentric approach by health African scientists
What does altruistic service imply for the duty to vaccinate? The pandemic significantly impacted older adults and people of colour Equally, the COVID 19 pandemic has further deepened social inequalities and provoked troubling economic crises for societies and individuals. In South Africa, the pandemic had an enormous impact on many individuals who depend on their daily income
Though altruism is one way in which solidarity has been conceptualised in the writings of some African scholars, it does not exclude reciprocal obligations, whereby individuals in a solidary group are responsive to each other

This paper appeals to the Afro-communitarian conceptions of solidarity to think critically about the duty (if any and in what ways) to vaccinate. Barbara Prainsack and Alena Buyx describe solidarity as “enacted commitment to carry the costs (financial, social, emotional, and other contributions) of assisting others with whom a person or persons recognise similarity in a relevant aspect”.
In sub Saharan Africa, one concrete way Africans have enacted this commitment to carry cost is exemplified by the phenomenon of black tax common in Southern Africa, whereby individuals who are well-off in a family help their indigent relatives
In African writings, altruistic service or altruism, reciprocity, and collective responsibility to promote the flourishing of all members are common themes often associated with this concept The idea that the normative ideal way of exhibiting solidarity entails (an attitude of) altruistic service has been defended by Thaddeus Metz Metz’s opinion is that, to exhibit solidarity entails a commitment to act to make others better people, sharing in their failures and successes, advancing their self realisation for their sake, and improving their situation, having been deeply aware of (and moved by) the other’s condition
The implication for COVID 19 vaccination is that, as others contribute towards limiting or mitigating the impact and spread of (as well as fatalities associated with) COVID 19 through vaccination, social distancing, wearing facemasks, and adhering to COVID 19 mitigation protocols, we ought to support them by doing the same The COVID 19 pandemic response will be robust and more effective if we complement each other’s efforts to limit or reduce the virus spread.
The Nigerian philosopher Segun Gbadegesin remarks: “every member is expected to consider themselves an integral part of the whole and to play an appropriate role towards achieving the good of all” COVID 19 pandemic has revealed that we are not isolated humans.
When activists and ethicists appeal to individuals to take COVID 19 vaccines because solidarity requires this, it is not merely for “altruistic” reasons or because they genuinely care for the well being of others Instead, it is because this costs less than the later intensive care that may be required due to COVID 19 complications or the burden on the health system
This paper argues that the principle of solidarity in Afro communitarianism tends to favour voluntary, rather than mandatory, COVID 19 vaccination Thus, if vaccination can be mandated from the Afro communitarian perspective, solidarity appears to be an inadequate principle to justify this position Read full study
Wits researchers involved: Rachana Desai, Gudani Mukoma, Merling Phaswana, Anza Thiba
In sub Saharan Africa, the reasons for low rates of COVID 19 vaccination and unwillingness to accept the vaccine vary, so country-specific solutions are needed Public health action that is humane, culturally relevant, and recognises the contribution of historical, structural, and other system dynamics has been called for.
To meet these objectives, countries should frame their remedial strategies based on approaches that WHO and the Lancet Commission on the future of health in sub Saharan Africa advocate for generating positive health behaviours.
Although vaccination rates have risen in the sub Saharan Africa region, vaccine resistance is a health related behaviour, and challenges to vaccine acceptance remain Consequently, as vaccine global supply and distribution inequities are overcome, countries must identify what individual factors and different sectors of society see as compelling reasons for and against being vaccinated and find new ways to engage undecided individuals
As WHO and others have identified, innovative approaches need to be sought that build trust and engage at risk populations, remediate insensitivity and reliance on so called top down directives, and promote strategies that are based on culturally sensitive dialogue and mutual respect Six WHO and Lancet Commission approaches encompass these criteria
and are directly applicable to strategies to remediate COVID 19 vaccine resistance:

Campaigns that inform, consult, involve, collaborate, and empower can engage stakeholders in subpopulations that are at particular risk or have specific concerns Fears about vaccine safety are commonplace. Second order ramifications of the pandemic (increased poverty, malnutrition, and sexual and gender related violence) impact many communities
The healthcare community warrants a particular focus
A WHO survey conducted in November 2021 across 25 African countries identified that only 27% of health workers were fully vaccinated, compared with 80% in 22 high income countries In addition, intended vaccine uptake in health workers was also low
Governments must identify trust enhancing triggers and use creative strategies to counter social media and internet generated misinformation that is undermining vaccine acceptance and, in parallel, reinforce the obvious not everything read online is true or reliable, and someone trusted should be asked to explain facts that are not understood. Read full article

settings under NHI and for other decision makers
This transformation will require comprehensive and inclusive planning with dedicated funding and regulation, and the provision of strong oversight mechanisms and leadership
Current HTA activities in South Africa
Despite policy intent to create HTA processes since 1996, there is still no formal national HTA institution in South Africa. In addition, there are no formalized and agreed HTA methods consistently used in South Africa; hence, outputs are likely to differ considerably, especially considering the varying motivations and decision making perspectives of different healthcare providers and funders
South Africa has embarked on major health policy reform to deliver universal health coverage through the establishment of National Health Insurance (NHI). The aim is to improve access, remove financial barriers to care and enhance care quality.
Health technology assessment (HTA) is explicitly identified in the proposed NHI legislation and will have a prominent role in informing decisions about the adoption and access to health interventions and technologies The specific arrangements and approach to HTA in support of this legislation are yet to be determined
Although there is currently no formal national HTA institution in South Africa, there are several processes in both the public and private healthcare sectors that use elements of HTA to varying extents to inform access and resource allocation decisions. Institutions performing HTAs or related activities in South Africa include the National and Provincial Departments of Health, National Treasury, National Health Laboratory Service, Council for Medical Schemes, medical scheme administrators, managed care organizations, academic or research institutions, clinical societies and associations, pharmaceutical and devices companies, private consultancies, and private sector hospital groups.
Abstract
Existing fragmented HTA processes should coordinate and conform to a standardized, fit for purpose process and structure that can usefully inform priority
There are however many processes that use elements of HTA to inform resource allocation and/or access decisions as seen in figure 1 below of the types of institutions with direct links to prioritization, pricing and procurement, or coverage decisions.

A credible, successful, and sustainable HTA process will require ongoing investment in personnel with a range of competencies While South Africa has this expertise across private and public sectors, an HTA process in support of NHI will require adaptation, expansion, and coordination of these competencies Read full study
PRICELESS SA researchers involved: Agnes Erzse, Safura Abdool Karim, Karen Joanne Hofman
The increasing availability of unhealthy processed food products is linked to rising rates of non communicable diseases and obesity in low and middle income countries Voluntary actions (VAs) are often adopted in lieu of regulating the composition, production, marketing and sale of unhealthy commodities, but their effectiveness is unclear
This realist review examines VAs adopted by the food and beverage industry in low and middle income countries We developed a conceptual framework and followed a three stage search to identify literature and VAs and, adhering to the Realist and Meta narrative Evidence Syntheses: Evolving Standards (RAMESES) guidelines, we produced a synthesized analysis of VAs VAs, often initiated in response to governments’ efforts to introduce regulations, were difficult to evaluate due to vague language and a lack of enforcement mechanisms
The review found no evidence indicating that VAs is effective in safeguarding public health Yet their implementation has resulted in weaker responses and policy substitution, and so we suggest that VAs have the potential to negatively influence public health and policy The United Nations should rescind its endorsement of industry involvement and mandatory measures should be favoured over VAs. Read full study
Female sex work contributes greatly to transmission dynamics in HIV epidemics in sub Saharan Africa
Modelling estimates suggest that less than 5% of new HIV infections in the country can be attributed to female sex workers; however, 42% of new infections are attributable to their male clients
In 2019, the first South African national cross sectional survey of female sex workers who were linked to sex worker programmes was conducted Estimating incidence in these women is particularly challenging as the cross sectional nature of the data, small sample sizes for the relevant analyses, uncertain accuracy of self reported data, and insufficient knowledge about this population to inform inputs that are required for incidence calculations By use of data and laboratory results from the national survey, the study aimed to estimate HIV incidence among female sex workers in South Africa and to describe the method adaptations used to enable this analysis

This study enrolled 3000 cisgender women aged at least 18 years, who had sold or transacted in sex in the preceding 6 months and worked in one of the districts that were studied A multistep sampling process was followed
Of 3005 female sex workers who were enrolled, 2999 had known HIV status and were included in the analysis Participants were aged 18 64 years, with a median age of 32 years The proportion of participants who self reported HIV infection on enrolment was lower than the proportion who were HIV positive on testing This study provides a baseline measure against which ongoing HIV programme efficacy can be measured Read full study


norms through engaging men to question traditional masculinity and found that the intervention significantly changed gender norms among men
A literature review indicated that community mobilisation has been found to change behavioural outcomes, including consistent condom use and HIV testing uptake, as well as some evidence that community mobilisation can improve uptake of services for sexually transmitted infections by addressing stigma and discrimination, creating social cohesion, raising community awareness, and extending social participation in target communities.
Wits researchers involved: Audrey Pettifor, Chodziwadziwa Whiteson Kabudula, Rhian Twine, Aimée Julien, Ryan Wagner, F Xavier Gómez Olivé, Stephen Tollman, Kathleen Kahn
Community mobilisation, engaging communities in a process to collectively enact change, could improve HIV testing and care engagement In South Africa, current rates fall below those needed for epidemic control. This study assessed whether community mobilisation increased HIV testing, linkage to care, and retention in care over time in intervention relative to control communities
HIV transmission can be decreased by reducing undiagnosed infections and expanding the early and consistent use of antiretroviral therapy (ART)

Treatment as Prevention has been proposed as the key to ending the HIV epidemic
To activate Treatment as Prevention in high prevalence countries, testing and care must be accessible and community members must be motivated to know their status, start ART, and maintain ART adherence South Africa introduced ART initiation regardless of CD4 cell count on Sept 1, 2016; however, only an estimated 52% of men and 64% of women living with HIV in 2017 were on ART, and only 43% and 58% had achieved viral suppression, respectively
Before designing this study, a randomised community trial was conducted to assess the impacts of community mobilisation on changing gender equitable
A cluster randomised controlled trial was conducted in villages in the Agincourt sub district of the rural Mpumalanga Province in South Africa. Villages were eligible if they had been fully enumerated in 2014, had not been included in previous mobilisation activities, and included over 500 permanent adult residents aged 18 49 years. Primary outcomes included quarterly rates of HIV testing, linkage to care, and retention in care documented from health facility records among residents of the intervention and control communities over the 3 year study period Intention to treat analyses employed generalised estimating equations stratified by sex.
Among women, HIV testing increased quarterly by 10,6% in the intervention communities and 9,3% in the control communities; increases were greater in intervention communities Quarterly linkage increased significantly among women in the intervention communities only Quarterly linkage fell among men in both arms but decreased significantly among men in the control communities Quarterly retention fell among women in both arms; however, reductions were tempered among women in the intervention communities Retention fell significantly among men in both arms with a difference in rates of decline.
The sum of these incremental, quarterly improvements achieved by addressing social barriers to HIV care engagement can impact epidemic control Read full study
Obesity predominantly affects populations in high income countries and those countries facing epidemiological transition. The risk of childhood obesity is increased among infants who had overweight or obesity at birth, but in low-resource settings, one in five infants are born small for gestational age (SGA). We aimed to study the relationships between (1) maternal metabolite signatures; (2) fetal abdominal growth; and (3) postnatal growth, adiposity, and neurodevelopment


There is increasing evidence that global SGA rates are associated more with the maternal exposome, including pre pregnancy and intergenerational effects, than genetic factors alone, because growth and neurodevelopmental patterns from conception to early childhood are similar across geographically diverse populations that have adequate health, nutrition, education, and breastfeeding Thus, the complexity of size at birth and its influence on later life is best understood by considering how the maternal exposome influences the biology of early human growth and development
Here, researchers aimed to study, in a large multinational pregnancy cohort, the relationships between (1) maternal metabolite signatures (as a measure of the exposome); (2) ultrasound derived fetal abdominal circumference trajectories and their feto placental blood flow patterns; and (3) postnatal growth, adiposity, and neurodevelopment.
The prospective, multinational, observational INTERBIO 21st fetal study was conducted in maternity units in Pelotas (Brazil), Nairobi (Kenya), Karachi (Pakistan), Soweto (South Africa), Mae Sot (Thailand),
and Oxford (UK) between Feb 8, 2012, and Nov 30, 2019
Obesity predominantly affects populations in high A total of 3598 women who initiated antenatal care before 14 weeks gestation were enrolled, identified by ultrasound dating, and monitored their pregnancies to delivery. The inclusion criteria for the women were: being 18 years or older, having a BMI of less than 35 kg/m 2, natural conception, and singleton pregnancy
After the dating ultrasonography, the women underwent an ultrasonography every 5±1 weeks until delivery using identical equipment
Neurodevelopment was assessed at the age of 2 years using the INTERGROWTH 21st Neurodevelopmental Assessment (INTER NDA), a multicultural, psychometric tool for children aged 22 30 months, designed to be implemented by non specialists across international settings, which measures multiple dimensions of early development using directly administered, concurrently observed, and caregiver reported items
A z score of 0 at 10 weeks’ gestation for each infant was added to highlight the growth trajectories relative to the initial ultrasonography and prevent grouping strictly by size
Each site's contribution to the total sample were: 397 (12 4%) of 3206 from Pelotas (Brazil), 647 (20 2%) from Oxford (UK), 554 (17 3%) from Soweto (South Africa), 502 (15 7%) from Karachi (Pakistan), 530 (16 5%) from Mae Sot (Thailand), and 576 (18·0%) from Nairobi (Kenya). Read full study
Association between fetal abdominal growth trajectories, maternal metabolite signatures early in pregnancy, and childhood growth and adiposity: prospective observational multinational INTERBIO-21st fetal study
Wits researcher involved: Siraaj Khan
Cases of baby swapping in South Africa (SA) are very rare. In 1996 the first of these cases, Clinton Parker v Administrator, Transvaal; Dawkins v Administrator, Transvaal, appeared before our courts The parties in that instance decided to keep the babies who had been erroneously given to them, but the plaintiffs were awarded compensation for the emotional shock and injury they endured as the result of the defendant’s negligence
In recent times the case of Child Law v NN and NS (GP), where the parties also decided to keep the children who had been erroneously given to them by the hospital staff.
These scenarios, while difficult, have had amicable conclusions, with the parents electing not to pursue custody of their natural children The situation would be more complex if either of the parties were to decide that they want their natural child back.
Several questions are pertinent here and will guide the discussion in this article Is it as simple as both ‘psychological’ parents returning the babies to their natural parents? Do the parents have a claim against the hospital staff? Unfortunately, there is not a wealth of legal precedent to assist the SA courts in this regard The article explores the jurisprudence that speaks to baby swapping, in an attempt to provide clarity and assistance in resolving these difficult cases
Legal issues
Both these cases gave rise to multiple legal issues, the most important being: what is in the best interests of the child? Other sub issues that were not expressly
considered by the courts included how are the interests of the ‘biological parents’ catered for, should the interests of the ‘perceived’ siblings of the child be taken into consideration, and does the child him or herself has a claim against the wrongdoers?

While the previous two cases do provide some guidance as to how instances of baby swapping should be dealt with, neither was decided by the Supreme Court of Appeal or the Constitutional Court, so they are not binding on the entire country We could also be faced with a situation where a ‘biological parent’ insists that he or she wishes to have the biological child returned and pursues further litigation
Cases of baby swapping that have come before our courts are few and far between Complex legal issues are raised, and difficult decisions need to be made SA legislation protects the rights of children and states that the rights of the child are paramount in any decision concerning the child.
Should this happen, we will again have to apply the ‘best interests of the child’ principle Foreign law may be consulted as provided for in the Constitution, and the rights of the biological parents as outlined by the US courts may be argued accordingly
the most accurate way to assess kidney function and to use this method to estimate the prevalence of kidney disease in African populations
Within each country, we conducted a population based study to determine CKD prevalence, henceforth known as the ARK CKD Population Prevalence Studies (Malawi n=5264, South Africa n=2020, and Uganda n=5979). From these cohorts, samples of the population were taken for the Iohexol Measured GFR Study; for this study, the target sample size for each country was 1000 participants, stratified by sex and eGFR stage
In each country, laboratories performed standardised serum creatinine measurements using an isotope dilution mass spectrometry traceable assay calibrated to standard reference material for creatinine The modified Jaffe method was used in Malawi and South Africa, and the enzymatic method in Uganda.
This study was conducted by the African Research on Kidney Disease (ARK) Collaboration, a partnership between research teams in Malawi, South Africa, Uganda, and the United Kingdom.
The burden of kidney disease in many African countries is unknown. Equations used to estimate kidney function from serum creatinine has limited regional validation We sought to determine the most accurate way to measure kidney function and thus estimate the prevalence of impaired kidney function in African populations.
In high income settings, black people have higher rates of kidney disease, but the prevalence in Africa is unclear Few countries in Africa have medical treatments or dialysis available for people with advanced kidney disease so the development of kidney disease leads to severe illness and premature death Earlier detection of kidney disease could reduce the number of people progressing to kidney failure Kidney function can be estimated by a simple blood test but the equations used to estimate kidney function, all of which were developed in high income settings, have limited validation in Africa despite widespread use
The primary objective of this study was to investigate
Participants who met all the following criteria were included: complete recordings of age, sex, height, and weight; exact times for administering iohexol (T0) and subsequent sampling; iohexol plasma concentrations at each timepoint and demonstrating a monotonic decline; pre administration and post administration syringe weights; and the serum creatinine concentration of 30 μmol/L or more.
The study measured GFR using iohexol plasma excretion in 3025 adults and included 2578 participants in the final analysis
The median age was 50 years South African participants were taller and weighed more and had greater obesity in women according to a BMI of 30 kg/m2 as compared with other countries assessed Ugandan participants had the lowest BMI Overall, 935 (36%) participants had hypertension; 138 (6%) had diabetes, with the highest prevalence among Malawian women; and 345 (13%) had HIV infection, with disproportionate seropositivity among South African women (136 [21%])
The results show that within three African countries, creatinine based eGFR equations substantially overestimate kidney function compared with mGFR Read full study

The Health Sciences Research Office established the Wits Alumni Diaspora Program in 2010 as an opportunity for alumni to give back their research expertise to Wits. The initiative has, since 2013, grown into a comprehensive collaborative network funded by the Carnegie Corporation of New York.

The goal of the Carnegie WITS Alumni Diaspora Programme is to enhance existing research networks by supporting collaboration and exchange partnerships with Wits alumni at international health research institutions.
Working with the Wits Faculty of Health Sciences, international partners have the opportunity to build upon strong foundations alongside established researchers, and to create additional collaborations with less established emergent researchers for the future.

world gradually realised that the impact of climate change would play out not just via melting glaciers and rising sea level, but also on individuals, their leisure and productive work that they do Professor Maloney’s 2011 work that projected the effect of a 2070 climate on leisure and labour activity was one of the first studies to highlight the effect that climate change will have on our everyday activities and, especially, on labour productivity
Shane Maloney, PhD MSc BSc HonProfessor Shane Maloney, a Wits alumnus, is a Professor in the School of Human Sciences at The University of Western Australia (UWA) in Perth

Prof Maloney joined Wits in the mid 1990s as a postdoctoral fellow in the Brain Function Research Group working with Professor Duncan Mitchell and Professor Helen Laburn. Since returning to Australia, he has maintained a strong link with Wits, as a visiting Professor and most recently as a Carnegie WITS Alumni Diaspora Programme Fellow
His work focuses on thermal physiology, especially exposure to extreme environments and the rhythm of body temperature as an index of circadian physiology.
It is becoming increasingly evident that a robust circadian rhythm is associated with better health outcomes, and that an attenuated rhythm is associated with pathology and disease
Prof. Maloney’s training at Wits under the mentorship of Prof Mitchell placed him in good stead, as the
He currently occupies his spare time investigating reproductive inefficiency in the Merino sheep The onset of breeding generally occurs in summer, and there is good evidence that high environmental temperature can impact the quality of sperm and eggs. Ewes may have a “silent oestrus”, which cannot be detected by the ram, potentially costing the sheep industry millions of lambs a year The five year project will describe the phenomenon and test interventions to improve reproductive outcomes.
At Wits, Prof Maloney maintains a healthy collaboration with members of the BFRG, led by Professor Andrea Fuller. He has recently co supervised two PhD graduates, Dr Manette Marais and Dr Maartin Strauss He currently supervises doctoral student, Ms Valery Phakoago, and assists several other students and postdocs in the group. The Carnegie WITS Alumni Diaspora Programme has facilitated several visits that included field research and workshops which Prof Maloney says was his highlight as he enjoys getting his hands dirty in the field
Since first participating in the Programme in 2016, the collaboration between Wits and UWA has resulted in 18 publications in leading journals of integrative physiology, and there are many more papers in the works
Muhammad Spocter, PhD MSc BSc Hon
Muhammad is a tenured full Professor of Anatomy and the Director of the Anatomy Graduate Program at Des Moines University (Iowa, USA). He serves on several scientific boards including the Science Center of Iowa, Ape Cognition and Conservation Initiative, Iowa Academy of Science, and is the Principal Executive Officer of the J.B. Johnston Club for Evolutionary Neuroscience.
Professor Spocter is a proud Witsie having completed his undergraduate (BSc 2001, BSc Hon 2002) and postgraduate training (MSc, 2004, PhD, 2007) in Biological Anthropology at the Wits Faculty of Health Sciences in the School of Anatomical Sciences He then completed a teaching fellowship at the University of California, Santa Barbara (2008) followed by postdoctoral training at George Washington University’s Center for the Advanced Study of Human Paleobiology (2008 2011)
He joined the faculty at Des Moines University (DMU) in 2011 where he teaches anatomy to students in the medical and allied medical disciplines and is actively engaged in research on the mammalian brain Professor Spocter is particularly engaged in comparative neuroanatomical studies mapping the brains of carnivora and apes and in helping us to
better understand the effect of domestication on the mammalian brain
Over the last few years, his collaborative links with the University of Witwatersrand have been enhanced through the generous support of the Carnegie WITS Alumni Diaspora Fellowship (2018, 2022) which has helped a joint team from Wits University (led by Professor Paul Manger) and DMU complete a comprehensive description of the brain of the highly endangered African Wild Dog
This research is significant as it has helped us to better understand the anatomical framework supporting complex behaviour in this species, which has important conservational and basic science value, whilst also establishing a necessary baseline for comparison with other wild and domesticated species, says Professor Spocter
Carnegie WITS Alumni Diaspora Programme funding has helped to enhance collaborative efforts between the two institutions, helping Prof. Spocter to establish ongoing links with several other young researchers in the Wits School of Anatomical Sciences This includes Dr Busi Maseko and Dr Brendon Billings, whom he has hosted in the USA and continues to mentor through overlapping teaching and research opportunities
He says that his own experiences and ambitions have shaped the spaces wherein he sees the need for impact:

As a first generation college student and one who took the unfamiliar path of pursuing a career as an educator and researcher at a tertiary institution, I understand the challenges faced by young faculty who are often drawn into many directions all at once
The opportunity to engage, support and mentor students and emerging faculty and help them persist in this career path, has been a rewarding experience for me and a somewhat intangible but important component of this stellar programme

They answered countless questions, gave blood and urine samples, and were repeatedly measured and scanned Their mothers participated, both as caregivers and individuals. Some fathers, teachers and school principals also completed questionnaires
“What to say at the end of the book? I find myself resisting drawing conclusions about the lives of ‘Mandela’s children’, who are 32 years old this year Most have the longer part of their lives ahead of them A lot could still happen, and the life of each one could change substantially,” says Richter.
Bt30 staff, some of whom have been employed by the project from its beginning, have been the mainstay of the study. They supported and encouraged mothers and their children to ensure that we retained their participation for as long as possible These staff members contributed to questionnaire development and the interpretation of findings. They gave each other courage when fieldwork was dangerous, and they helped participants and their families when no one else would
The book will be available through Amazon and Takealot and proceeds will fund postgraduate students working with longitudinal data Book summary
The Birth to Thirty study (Bt30) tracks the lives of some 3 000 people born in South Africa in the early 1990s and is known affectionately as ‘Mandela’s Children’. These children are now 32 years old.

The people, their stories, and those who care In the book, Professor Linda Richter weaves together the stories, the people, and the science that make up Bt30 She expertly positions the personal contributions from participants and staff with key scientific findings and trends from the data, within their historical and contemporary context
“I am very grateful that I had the opportunity to lead and contribute to Bt30 It is one of the big achievements of my career,” says Richter “My most cherished dream would come true if one our students, with even bigger dreams, secured a large grant to continue to follow up the cohort and their children and even, their children’s children We have so many more research questions that need answering as these young adults progress to older ages ”
The participants, to whom the book is dedicated, completed more than 22 rounds of data collection
PRICELESS SA senior researcher, Dr Teurai Rwafa, has co-edited a book titled Primary Health Care in Southern Africa: A Comprehensive Approach.
This book is published by Oxford University Press and is an accessible introduction to the fundamental concepts, principles and components of comprehensive Primary Health Care (PHC)
Health professionals involved in post graduate studies in public health, along with professional nurses, doctors, health promoters, environmental health practitioners and allied professionals, will find it useful

This book, authored by Wities Rochelle Keene and Emeritus Professor Cedric Bremner, with historical introductions by Simmone Horwitz; describes the contributions made by 138 South African doctors and medical scientists from 1890 to 1990
Despite the academic and cultural boycott of South Africa during the apartheid years, South Africans made astonishing contributions to many fields of biomedicine The authors record some of these and explain their significance in advancing medical care globally.
With the foreword by another remarkable Witsie and Vice Chancellor of the University, Professor Zeblon Vilakazi, he attributes the excellence highlighted in the book as a success story belonging to the country
The book is a tribute not only to Wits University but to South African medical research in general As such, it should serve as a source of pride not only for the University but for all South Africans

This entry describes African views of moral status in detail First, it contrasts African views of moral status with Western ones that the readers might be familiar with; then, it explores the strengths and limitations of two prominent ones, as well as one improvement to these two prominent African views of moral status

In a dominant Western moral equality threshold conception, moral status applies equally to individuals who possess the characteristics sufficient to be called a person Though a respect based or individualist account does a good job at explaining the source of an entity’s moral worth, it may, however, not be very well suited to account for the differences in moral considerability since what counts from the respect based threshold account of moral status is whether the entity has the capacity in question and not whether the entity excels at it.
Like many relational theories, African philosophy grounds the source of moral status not in intrinsic factors about the entity, but relationships Generally, there are three ways relational theories ground moral status: to the extent that one is a part of the relationship of solidarity (notably Western relational theories, particularly Ethics of Care), to the extent that one is part of an existing relationship of identifying and exhibiting solidarity (notably African moralized forms of relationalism), and finally, to the extent that one can be part of a relationship of identifying and exhibiting solidarity (notably African modal forms of relationalism)
A modal relational account of moral status is an improvement to the African relational theory of moral status. Based on a modal relational account, entities with full moral status tend to be instrumentally valuable, that is, their capabilities are vital for maintaining communal relationships itself, and are more morally considerable than others
 Wits researcher involved: Cornelius Ewuoso
Wits researcher involved: Cornelius Ewuoso
The development of brand new drug molecules that form part of sophisticated Drug Discovery programs is relatively expensive, time consuming and comes with a very high risk of failure, especially for LMICs Hence, improving the safety to efficacy ratio of promising new/existing drugs by using novel methods of drug delivery can enhance, individualize
Congratulations to Professor Yahya Choonara, who recently received a leading international accolade recognizing his outstanding research and significant contributions to the Pharmaceutical Sciences globally.
The Bureau of the International Pharmaceutical Federation (FIP) selected Prof. Choonara for the 2022 FIP Distinguished Pharmaceutical Science Award conferred at the 80th FIP World Congress of Pharmacy and Pharmaceutical Sciences held recently in Seville, Spain The FIP represents over 4 million Pharmacists and Pharmaceutical Scientists around the world.

As an advocate of pharmaceutical innovation, Prof Choonara’s persistent leadership in the Pharmaceutical Sciences on the continent is making an impact on global health and at the forefront of producing advanced life saving 21st century medicines for infectious, hereditary and lifestyle diseases
He leads the Wits Advanced Drug Delivery Platform (WADDP) Research Unit, a flagship unit of the University and Africa’s first, largest and only entity in the domain contributing to the design of novel targeted drug (and/or bioactive) delivery systems, nanomedicine, functional biomaterials and regenerative medicines Drug delivery science is the method and process of formulating a newly discovered (or existing) drug (or bioactive) to achieve a better therapeutic effect in the human body (i e improved bioavailability)
and revolutionize drug therapy. This is where innovations at the WADDP are changing conformist thinking and pursued vigorously by Prof Choonara’s scientific team leading to many breakthroughs
As a Personal Professor of Pharmaceutical Sciences, a Tier 1 South African National Research Foundation Chair in “Pharmaceutical Biomaterials and Polymer Engineered Drug Delivery Technologies” he holds the largest pharmaceutical product patent portfolio (43 in total) aimed at providing patient centric drug therapies for unmet therapeutic needs including special populations His inventions include a WaferMat (the world’s fastest dissolving matrix), a VagiTab, Nanomedicine and BioInspired NeuroTherapeutics
He is also the first South African Pharmaceutical Scientist and Pharmacist to receive both, this FIP Award and the Department of Science and Innovation of South Africa Top Intellectual Property Creator Award, one of the country’s highest awards for distinguished contributions to innovation.
Prof Choonara is passionate about developing the next generation of Pharmaceutical Scientists for South Africa and the continent and has graduated >110 postgraduates and mentored >18 postdoctoral fellows from nine countries and currently mentors several emerging pharmaceutical scientists at various academic institutions in South Africa and on the continent pursuing a career in pharmaceutical product development (including nanomedicine)
It is a cold Wednesday morning as Shabir Madhi makes his way through the boom gates of the Chris Hani Baragwanath Academic Hospital in Soweto, Johannesburg To first time entrants, the world's third largest hospital presents a frustrating labyrinth of dead ends and wrong turns. However, having made the same journey each day for more than 25 years, Madhi navigates the roads with ease Just a short drive from the Clinic Road entrance is the home of the Wits Vaccines and Infectious Diseases Analytics Research Unit (Wits VIDA), where South Africa and Africa’s first Covid 19 vaccine trials (Oxford/AstraZeneca and Novavax Covid 19 vaccine) took place
On first inspection, one could be forgiven for thinking that the tall, stark building visible from any vantage
point in the hospital precinct would be best suited as the backdrop for a dystopian movie. However, appearances can be deceiving, as one soon learns when engaging with Madhi As the Director of Wits VIDA, in addition to his role as Dean of the Faculty of Health Sciences and Professor of Vaccinology at Wits University, Madhi wears multiple hats with a rare mix of idealism and pragmatism
A National Research Foundation A rated scientist and a paediatrician, Madhi's research has focused on the epidemiology and clinical development of vaccines against pneumonia and diarrhoeal disease, as well as vaccines for pregnant women to protect the mother and her offspring These studies have informed World Health Organization recommendations on the use of the lifesaving pneumococcal conjugate vaccine and rotavirus vaccine in children, and flu vaccination of pregnant women
In 2020, the focus of Madhi’s research necessarily pivoted to Covid 19 vaccines. Never one to shy away from controversy, Madhi has been an outspoken, articulate and ardent advocate of Covid 19
vaccination, as well as for increased access to these and other vaccines in Africa. This is likely why, in quiet deference to his scientific and research prowess, colleagues and staff alike refer to him as ‘Prof’
His demeanour, although reserved, is passionate when it comes to his work. Wits VIDA days are crammed with two hour long clinical trial meetings, alternating between Covid 19 and maternal/paediatric studies, followed by updates from study coordinators and medical officers. Afternoons are set aside for surveillance and Covid 19 studies, in between conversations with students and management
Since taking on the role of Dean of the Wits Faculty of Health Sciences 18 months ago, Madhi has had to relinquish some of the time spent at Wits VIDA.
Although not as dynamic as his previous role, the deanship has afforded him the opportunity to influence change in a new way. Part of his strategic vision includes curriculum reform and establishing a Wits Infectious Diseases and Oncology Research Institute
On accepting his NSTF South 32 Lifetime Achievement Award, Madhi said that the Covid 19 vaccines had saved an estimated 20 million lives
He dedicated his award to the 300 000 South Africans who lost their lives to Covid 19, partly due to the stymied national vaccine rollout programme, and to the estimated thirteen million people worldwide who succumbed to this now vaccine preventable disease

In 2021, Madhi received the South African Medical Research Council Platinum Medal Lifetime Achievement Award, and the Academy of Sciences South Africa Science for Society Gold Medal He serves on multiple international advisory committees, including at the World Health Organization.
Written by Antonia Appel for IOL Business ReportHE2RO researcher is a recipient of the Boston University School of Public Health Excellence in Research Early Career Award 2022

Prof. Paul Manger won the 2022 Faculty of Health Sciences Best Postgraduate Supervisor Award. His research focuses on the evolution of brain and behaviour – evolutionary neuroethology - of African mammals. Prof. Manger, his colleagues and numerous postgraduate students examine the structure of African and other mammal brains to investigate how brains change and how they stay the same in different phylogenetic lineages and mammals showing major morphological variations. The laboratory has examined the brains of very small mammals (such as Mus minutoides, with a brain weighing in at 275 mg) through to the brains of African elephants (which weigh in at around 5 kg). These studies are building a fundamental understanding of the processes of brain evolution and how they relate to behaviour in mammals.
To undertake this type of broad-based comparative neuroscience, the laboratory has established the first major brain bank in the southern hemisphere and has collected the most well-prepared specimens of mammal brains from over 300 species, allowing for the use of modern neuroanatomical methods.

An Honorary Degree of Doctor of Sciences (Medicine) was conferred on Prof Rees by the University of London She was also named as one of the Standout voices in African public health by the Harvard School of Public Health



Department of Pharmacy & Pharmacology researcher was inducted into the Hall of Fame by the SA Master’s Volleyball Association for his outstanding contributions to the development of Volleyball in South Africa



Department of Pharmacy & Pharmacology researcher was selected and invited by the Chair of the Science and Technology in Society (STS) Forum to the 19th Meeting of the STS Forum in Kyoto, Japan from 2 4 October 2022
The WADDP team was selected to participate in the 2022 Gauteng Accelerator Programme (GAP) Innovation Competition in the Biosciences category
See patent

Prof Dietrich was awarded an amount of USD70,000 for a research proposal.
Less than 30 % of the South African population has received a COVID 19 vaccine and as of 22 February 2022, just under 1 3 million South African children aged 12 17 years had been vaccinated
The South African population consists largely of young people, as is similar across Africa Prompted by conversations with young people, this application proposes three linked objectives, which were informed by continuous consultation with a youth led community advisory board endorsing its relevance and bringing focus to the scientific approach
The immediate aim is to better understand how information about COVID 19 is accessed and spread in the response to circumvent vaccine hesitancy in young people
Dr Levy received the ASH Global Research Award, coupled with support for her project on Democratizing Digital Pathology.
In addition to the ASH Global Research Award, Dr Levy has received a Seed Funding grant from the Wits Faculty of Health Science for her project
The research aims to develop an automated system for peripheral blood smear analysis using Artificial Intelligence and Deep Learning The project is in collaboration with VitruvianMD, a medical technology company founded by Wits graduates that combines bio medical engineering and state of the art Artificial Intelligence to make healthcare more accessible for all
I am so excited and honoured to have received this award. The grant will support the roll out of innovative, low cost Telepathology for regional NHLS laboratories in South Africa,” says Dr Levy

Miss Kim is selected for entry into The Global Undergraduate Awards 2022 Programme in the Chemical & Pharmaceutical Sciences category
 Hon Professor Osman Sankoh
Hon Professor Osman Sankoh
The World Bank funded the establishment of three research sites of the Harmonizing and Improving Statistics in West Africa Project (HISWA) in Sierra Leone, led by Prof Sankoh

“I thank God that the World Bank has made our Stats SL dream come true with the $2m over an initial 3 year period,” said an overexcited Sankoh
Dr Jenny Coetzee & Minja Milovanovic
Dr Coetzee (PhD) and co investigator Miss Milovanovic were awarded a USAID PEER Research Award for their proposal “HIV incidence estimation among female sex workers in South Africa: a multiple methods analysis of cross sectional survey data”

In striving to provide our students with well designed online and blended courses, Wits has partnered with Quality Matters (QM), a leading body in the quality assurance of blended and online courses in Higher Education QM membership benefits include discounted rates on professional learning initiatives, access to the QM research database containing literature and resources, and standards and tools to develop, evaluate, and improve the quality of course design
Discover, with the support of Dr Robin Drennan, Director for Research Development in the University Research Office, how to write a persuasive proposal for research funding Having understood that every funder is contractually bound to deliver a return of some sort on the funds under their management, it is plain to see several ‘magical buttons’ that will get you funding Some of these buttons are explicit but others are not. The trick is to find them.
The workshop material also covers the differences between a research plan, a problem statement, rationale and motivation, and aims and objectives, all elements of typical proposals The importance of selecting appropriate reviewers, leaving nothing to chance and the need to make every part of the proposal supportive of your bid for funding are also discussed Finally, the workshop explores differences in writing styles: Persuasive writing used in proposals and standard writing techniques used in the publication of research outputs Virtual, 09h00 13h00.
The call for applications for the 2022/2023 Dr Lindiwe Makhunga fieldwork research grant are now open The grant is valued at R150 000 and is open to students currently registered for PhD studies at Wits University
Dr Jacqueline Weyer will be presenting
Meeting ID: 878 4877 7740
17h30
Monkeypox: the emerging
Theme: “Research
threat
world”
The 13th CHPA
invitation
open to
be held at the Wits School of Public Health
registrars
in the







